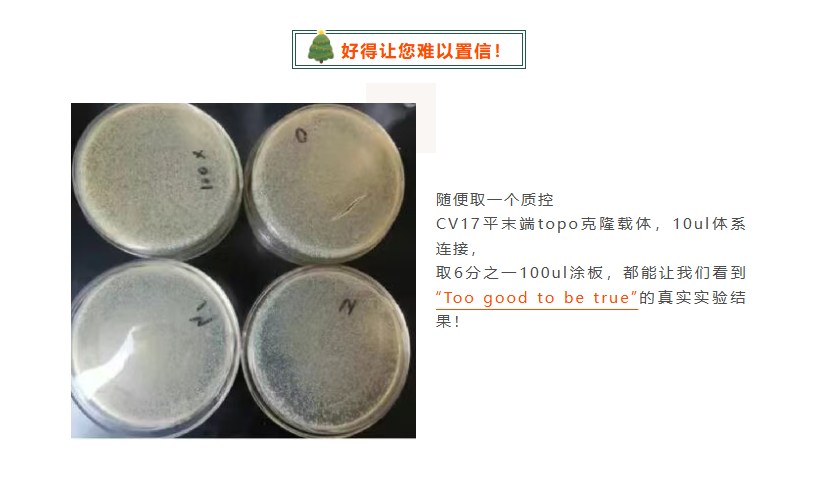
零背景pTOPO-Blunt Simple平末端克隆试剂盒/

零背景pTOPO-Blunt Simple平末端克隆试剂盒/
不含多克隆酶切位点MCS万千商家帮你免费找货
0 人在求购买到急需产品
- 详细信息
- 用户评价
- 文献和实验
- 技术资料
- 英文名:
Zero Background pTOPO-Blunt Simple Cloning Kit
- 库存:
充足
- 供应商:
Aidlab
- 规格:
80次×10μl
产品介绍:
本制品和传统的T4连接酶原理不同,它利用了Topoisomerase可以在瞬间(几秒钟-几分钟)、高效(接近100%)连接DNA片段的原理采用本公司独创的工艺制成。
1. 平末端PCR产物不需要先加A,在瞬间(几秒钟-几分钟)完成平末端PCR产物连接。
2. 特制的新型载体质粒大小仅仅不到2kb,充分发挥了TOPO载体越小,可容纳片段越大的优势,最大限度提高了大片段连接效率;连接后质粒大小比传统载体小2kb以上,质粒越小,转化效率越高,极大的提高了各种片段连接后的转化子数量。
3. 采用氨苄抗性载体只需0-10分钟复苏时间,比卡那抗性载体1小时复苏时间缩短6倍。
4. 最快可以省略1小时复苏步骤,热休克冰浴后,不用加LB复苏,直接将感受态涂板即可。从连接到涂板全程只需15分钟。
5. 自杀基因零背景原理,无自连假阳性,无需繁琐蓝白斑筛选和菌落PCR筛选。大部分情况下随机挑一个克隆便是有插入的(接近100%)。
6. 连接长片段能力远超传统Blunt克隆载体,可连接长达10kb片段(例如连接5kb片段,也可能达到挑10个菌落,至少8个是有插入的效果),是新一代世界领先的简单、快速、零背景免筛选的TOPO Blunt平末端克隆载体。
本制品在克隆插入位点两侧不含多克隆酶切位点(Simple),需要时可在PCR扩增引物上导入合适的酶切位点。此时如果使用PCR扩增引物导入的酶切位点进行酶切时,酶切反应将不会受到载体上其它多克隆酶切位点影响,可大大提高酶切效率,增加亚克隆成功率。
试剂盒组成、储存、稳定性:
| 试剂盒组成 | 20/40 次(CV1701) | 80/160 次(CV1702) |
| pTOPO-Blunt Simple Vector(30 ng/ul) | 20ul | 80ul |
| 1 kb Control(40 ng/ull) | 5ul | 5ul |
| 10 × Enhancer | 20ul | 80ul |
▲ 本 TOPO 载体连接体系按照 10 μl 一次计算可以用 20 次,如果按照其它公司产品5 μl 一次计算,使用次数可以增加一倍,20 次可用 40 次。
▲ -20°C 储存,至少 12 个月。冰袋运输,1-2 天置于室外常温不影响质量。
操作步骤:
1. 连接反应的准备:
PCR引物使用正常设计的引物即可,不需做任何改变(不能用磷酸化引物)。使用扩增产物是平末端的高保真聚合酶系列扩增(如Pfu、Phusion、A8 Mix、A9 Mix)PCR产物一般建议胶回收纯化(货号:DR01),这样可以避免后续可能的问题。如果PCR产物仅有目的条带、无非特异条带和引物二聚体,也可尝试直接进行连接反应。如果是以质粒为模板的PCR产物则最好进行纯化,因为模板质粒也可能长出菌落(但不是想构建的目的载体)。
2. 连接反应:
1) 室温设立 10 μl 连接体系(建议用 0.2 ml PCR 管,PCR 仪器控温):纯化后的 PCR 产物/或者 1 μl 1 kb Control 0.5-5 μlpTOPO-Blunt Simple Vector 1 μl10 × Enhancer 1 μl
灭菌水 X μl总体积 10 μl加完试剂后,用移液器轻轻吹打混匀或者轻弹管底混匀,低速瞬时离心收集所有液体在离心管底,注意此步骤不能在冰上进行,只能在室温(25°C-37°C)进行。
▲ 如果使用 5 μl 体系连接,各成分按照比例减半使用,使用次数可以加倍。不同大小插入片段的推荐用量(注意过量太多了,反而导致转化子减少):插入片段大小(bp) 推荐用量(ng)100-1000 10-401000-2000 40-802000-5000 80-180
2) 37°C 连接 5 分钟(建议置 PCR 仪器上控温)。▲ 本载体推荐室温(25°C-37°C)5 分钟完成连接。长片段或者连接困难片段可以延长连接时间到 10-15 分钟,温度可选 37°C,可显著增加转化子数量。
3) 连接产物置于冰上备用。立即接标准的感受态转化步骤或快速转化步骤。
3. 快速转化:
1) 感受态细胞从-80°C 拿出,迅速插入冰浴中,解冻融化(约 1-3 分钟)。
2) 立刻加入 5 μl 连接液(最多可 10 μl 连接液全加入,只要体积不超过感受态细胞体积的 1/10),手指拨打(Flick)离心管底轻轻混匀(避免用枪吸打),冰浴放置 5 分钟。
3) 热休克:42°C 水浴热休克 60 秒,迅速放回冰浴静置 2-3 分钟,该过程不要摇动离心管。
▲ 本公司技术连接效率比竞争对手高 10-100 倍,所以如果后续发现转化子很多,甚至长糊板子,做完热休克步骤后,可以省略步骤 4(复苏),直接将热休克冰浴后的感受态细胞涂板,培养过夜即可。这样从连接到涂板全过程仅需要 15分钟,超快速流程极大的简化了操作,缩短了时间。
4) 复苏(可选步骤):加 500 μl LB 或者 SOC 培养基(不含抗生素),37°C 200 rpm 振荡培养 10-20 分钟。
▲ 根据我们的经验,一般可以直接将培养基(如从冰箱取出温度低,应事先置37°C 温箱回温至 22°C-37°C) 加入到感受态细胞的 1.5 ml 离心管,盖上离心管盖,水平固定在振荡培养箱中振荡培养复苏即可,不需要转移到试管培养复苏。
▲ 一般商品化的感受态细胞不超过 2 kb 插入片段情况下,热休克后 10-15 分钟复苏可以得到足够多转化子,如果使用实验室自制的感受态效率低、或者转化子少、插入片段长的情况下可以提高复苏时间到 30-60 分钟以得到更多的转化子。
▲ 本公司技术连接效率比竞争对手高 10-100 倍,追求最简单最快速的用户可以尝试省略步骤 4(复苏), 直接将热休克冰浴后的感受态细胞涂板,培养过夜即可。熟悉超快速流程后,以后这样从连接到涂板全过程仅需要 15 分钟,超快速流程极大的简化了操作,缩短了时间。
5) 取 100-200 μl 菌液涂板(培养板含氨苄西林 100 μg/ml),培养过夜。
4. 转化子的筛选鉴定:
本制品采用自杀基因零背景原理,无插入自连的细菌会自杀无法生长,因此几乎没有假阳性,一般情况下,可以达到所见即所得,只要是长出来的菌落正常(不是污染的杂菌,转化子数量也不算太少),基本就 100%包含插入。因此插入片段不超过 2-3kb 的情况下强烈建议不做菌落 PCR 鉴定,直接挑 1-2 个菌去测序。
1). 一般本公司 TOPO 载体阳性率非常高,所以菌落生长正常,数量也不是太少的情况下建议直接去测序(强烈建议不做菌落 PCR 筛选)。注意测序引物不能采用 M13(-47)/M13(-48)通用引物测序。
2). TOPO 载体的菌落 PCR 结果容易出现假阴性(就是菌 P 失败显示没有插入或者扩增大小不对,实际却是有插入的)。因此在使用菌 P 鉴定的情况下,如菌 P 结果阳性,一般可以相信此结果。如结果是阴性,或者显示扩增出大小和预期不符合,一般不可相信,要考虑到菌 P 结果假阴性的可能,需要直接去测序鉴定,测序成功的完成实验;测序不成功的可以进一步提取质粒跑电泳看大小,或者酶切鉴定来确认。
3). 用上述培养的白色菌落的菌液抽提质粒,插入片段较大的情况下,直接跑电泳看质粒大小就直接能鉴定出有插入的质粒,还可用载体骨架上酶切位点如 ApaI/BglI/BsaHI,或者插入片段上引入的酶切位点酶切鉴定,琼脂糖凝胶电泳检查片段大小,确定是否含有目的片段。
pTOPO-Blunt Simple 载体图谱:

pTOPO-BLUNT Simple 载体克隆位点序列:

风险提示:丁香通仅作为第三方平台,为商家信息发布提供平台空间。用户咨询产品时请注意保护个人信息及财产安全,合理判断,谨慎选购商品,商家和用户对交易行为负责。对于医疗器械类产品,请先查证核实企业经营资质和医疗器械产品注册证情况。
 用户评价
用户评价 暂无用户评价
暂无用户评价 文献和实验
文献和实验Interspecific Recombination Between Zucchini Tigre Mosaic Virus and Papaya Ringspot Virus Infecting Cucurbits in China

/穿梭质粒) 第二步:再看筛选标记,如抗性,决定使用什么筛选标记。 (1)Ampr 水解β-内酰胺环,解除氨苄的毒性。 (2)tetr 可以阻止四环素进入细胞。 (3)camr 生成氯霉素羟乙酰基衍生物,使之失去毒性。 (4)neor(kanr)氨基糖苷磷酸转移酶使 G418(长那霉素衍生物)失活 (5)hygr 使潮霉素β失活。 第三步:看多克隆位点(MCS)。它具有多个限制酶的单一切点。便于外源基因的插入。如果在这些酶切位点以外有外源基因的插入,会导致某种标志基因的失活,而便于筛选
商品化的T载体有很多。本实验采用TaKaRa公司的pMDTM18-T Simple Vector。这个载体以pUC19载体为基础,消除了pUC18载体上的多克隆酶切位点,经EcoRⅤ酶切后在两侧的3'端添上“T”制备而成(见附录1)。由于本载体上消除了多克隆酶切位点,克隆后的PCR产物将无法使用载体上的限制酶切下,需要在PCR扩增引物上导入合适的酶切位点。 【试剂与器材】
(3)camr:生成氯霉素羟乙酰基衍生物,使之失去毒性。 (4)neor(kanr):氨基糖苷磷酸转移酶,使G418(卡那霉素衍生物)失活。 (5)hygr:使潮霉素β失活。 第三步:看多克隆位点(MCS)。它具有多个限制酶的单一切点,便于外源基因的插入。如果在这些位点外有外源基因的插入,会导致某种标志基因的失活,而便于筛选。决定能不能放目的基因以及如何放置目的基因。 第四步:再看外源DNA插入片段大小。质粒一般只能容纳小于10Kb的外源DNA
 技术资料
技术资料需要更多技术资料 索取更多技术资料
资料下载:
CV1702发表文献-ZTMV 与 PRSV 在中国葫芦科作物中的种间重组.pdf 附 (下载 0 次)
2025-8-22-19595498298.pdf 附 (下载 1 次)
请 [登录] 后再下载!





